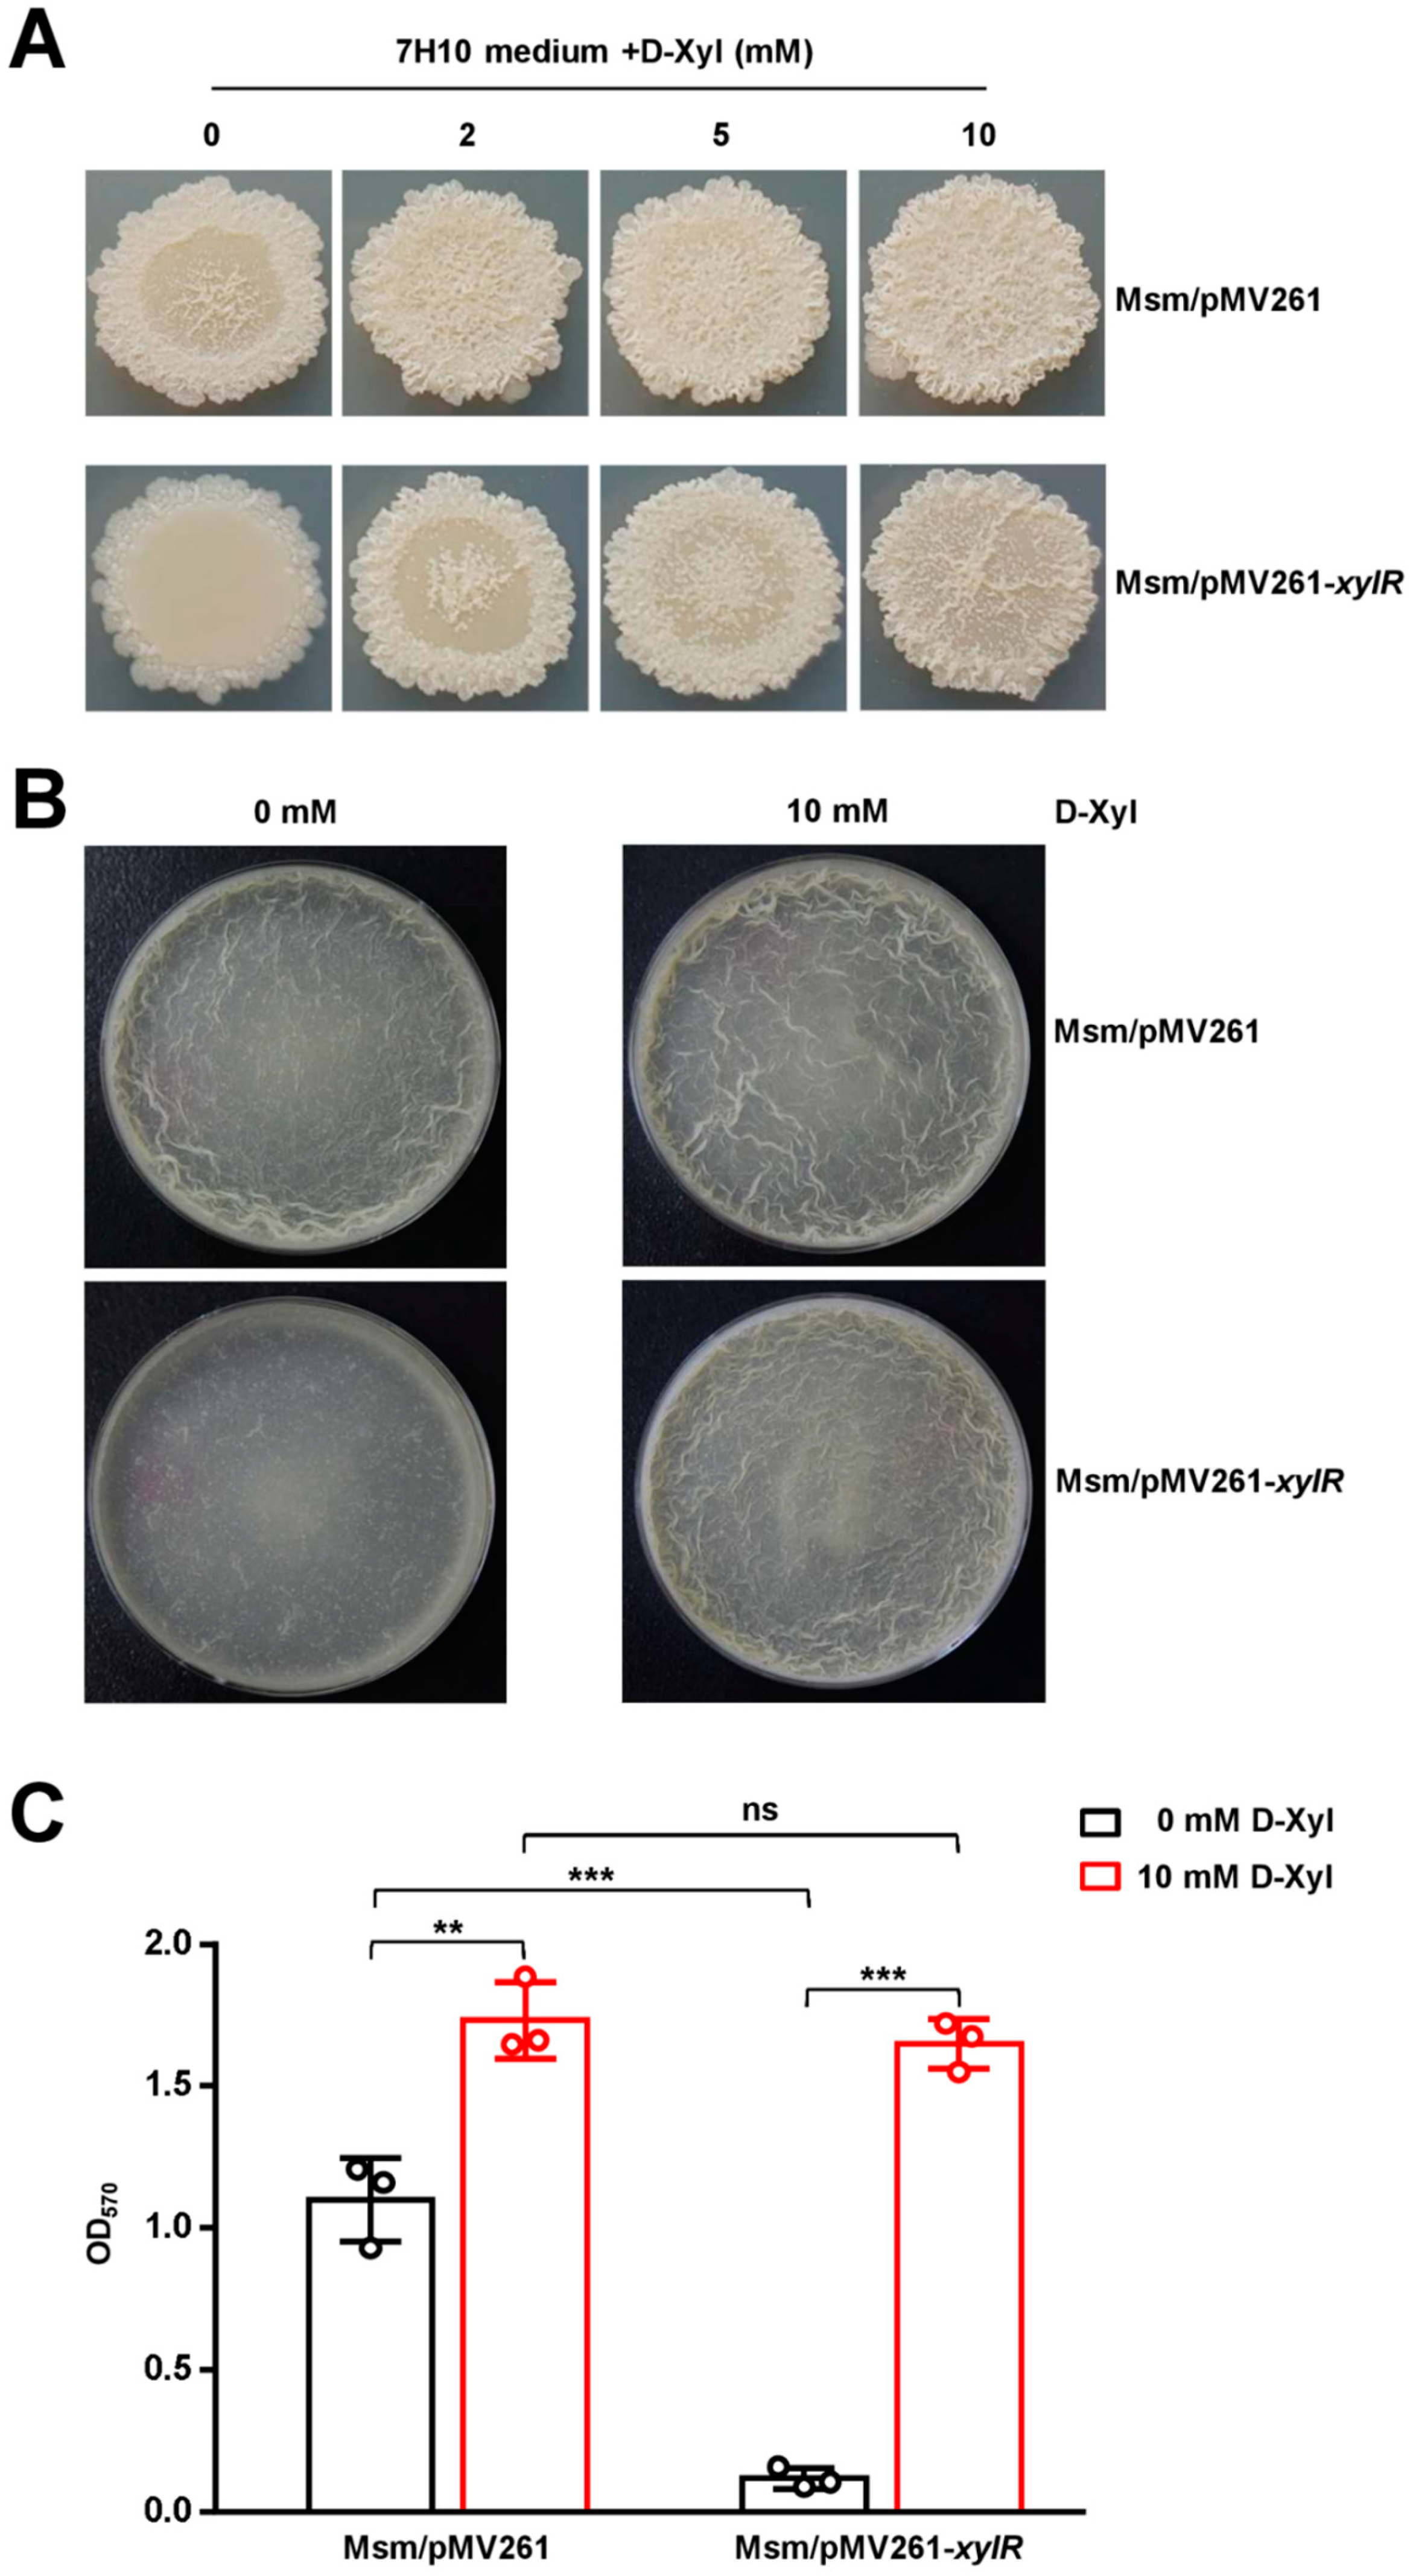
Ijms 24 07086 g006 Ijms 24 07086 g006

D-Xylose Blocks the Broad Negative Regulation of XylR on Lipid Metabolism and Affects Multiple Physiological Characteristics in Mycobacteria
Abstract
1. Introduction
2. Results
2.1. XylR Negatively Regulates the Expression of Its Own Gene Operon
2.2. D-Xylose Inhibits the DNA-Binding Activity of XylR and Effectively Counteracts the Negative Regulation of XylR
2.3. XylR Is a Negative Regulator and Broadly Affects the Expression of Lipid Metabolism Genes in M. smegmatis
2.4. XylR Negatively Regulates the Synthesis of Lipid in M. smegmatis
2.5. XylR Regulates Bacterial Size, Colony Phenotype, and Biofilm Formation in M. smegmatis
2.6. D-Xylose Has a Contrary Regulatory Role to XylR for the Colony Phenotype and Biofilm Formation in M. smegmatis
2.7. D-Xylose Can Effectively Counteract xylR-Dependent Drug Resistance and Cell Aggregation
2.8. XylR Attenuates M. bovis BCG Survival in the Host
3. Discussion
4. Materials and Methods
4.1. Cloning, Expression, and Purification of Recombinant Proteins
4.2. Bacterial One-Hybrid Assays
4.3. Electrophoretic Mobility Shift Assay (EMSA)
4.4. Chromatin Immunoprecipitation Assay
4.5. Footprinting Assay
4.6. β-Galactosidase Activity Assays
4.7. Isothermal Titration Calorimetry (ITC) Analysis
4.8. Transcriptomic Analysis
4.9. GC/MS Assays for Detecting the Lipids of M. smegmatis
4.10. Morphological Observation of Different Strains
4.11. Observation of Bacterial Morphology through Scanning Electron Microscope
4.12. Observation and Quantification of Biofilm
4.13. Morphological Observation and Determination of Mycobacterial Growth Curves
4.14. Intracellular Survival Assays
4.15. Mouse Infection
5. Conclusions
Supplementary Materials
Author Contributions
Funding
Institutional Review Board Statement
Informed Consent Statement
Data Availability Statement
Conflicts of Interest
References
- Ruchala, J.; Sibirny, A.A. Pentose metabolism and conversion to biofuels and high-value chemicals in yeasts. FEMS Microbiol. Rev. 2021, 45, fuaa069. [Google Scholar] [CrossRef] [PubMed]
- Rubin, E.M. Genomics of cellulosic biofuels. Nature 2008, 454, 841–845. [Google Scholar] [CrossRef] [PubMed]
- Desai, T.A.; Rao, C.V. Regulation of arabinose and xylose metabolism in Escherichia coli. Appl. Environ. Microbiol. 2010, 76, 1524–1532. [Google Scholar] [CrossRef] [PubMed]
- Dahl, M.K.; Schmiedel, D.; Hillen, W. Glucose and glucose-6-phosphate interaction with Xyl repressor proteins from Bacillus spp. may contribute to regulation of xylose utilization. J. Bacteriol. 1995, 177, 5467–5472. [Google Scholar] [CrossRef]
- Stephens, C.; Christen, B.; Watanabe, K.; Fuchs, T.; Jenal, U. Regulation of D-xylose metabolism in Caulobacter crescentus by a LacI-type repressor. J. Bacteriol. 2007, 189, 8828–8834. [Google Scholar] [CrossRef]
- Song, S.; Park, C. Organization and regulation of the D-xylose operons in Escherichia coli K-12: XylR acts as a transcriptional activator. J. Bacteriol. 1997, 179, 7025–7032. [Google Scholar] [CrossRef] [PubMed]
- Ni, L.; Tonthat, N.K.; Chinnam, N.; Schumacher, M.A. Structures of the Escherichia coli transcription activator and regulator of diauxie, XylR: An AraC DNA-binding family member with a LacI/GalR ligand-binding domain. Nucleic Acids Res. 2013, 41, 1998–2008. [Google Scholar] [CrossRef] [PubMed]
- Kreuzer, P.; Gartner, D.; Allmansberger, R.; Hillen, W. Identification and sequence analysis of the Bacillus subtilis W23 xylR gene and xyl operator. J. Bacteriol. 1989, 171, 3840–3845. [Google Scholar] [CrossRef]
- Sizemore, C.; Wieland, B.; Gotz, F.; Hillen, W. Regulation of Staphylococcus xylosus xylose utilization genes at the molecular level. J. Bacteriol. 1992, 174, 3042–3048. [Google Scholar] [CrossRef]
- Rygus, T.; Hillen, W. Catabolite repression of the xyl operon in Bacillus megaterium. J. Bacteriol. 1992, 174, 3049–3055. [Google Scholar] [CrossRef]
- Scheler, A.; Hillen, W. Regulation of xylose utilization in Bacillus licheniformis: Xyl repressor-xyl-operator interaction studied by DNA modification protection and interference. Mol. Microbiol. 1994, 13, 505–512. [Google Scholar] [CrossRef] [PubMed]
- Lemassu, A.; Ortalo-Magne, A.; Bardou, F.; Silve, G.; Laneelle, M.A.; Daffe, M. Extracellular and surface-exposed polysaccharides of non-tuberculous mycobacteria. Microbiology 1996, 142 Pt 6, 1513–1520. [Google Scholar] [CrossRef]
- Cole, S.T.; Brosch, R.; Parkhill, J.; Garnier, T.; Churcher, C.; Harris, D.; Gordon, S.V.; Eiglmeier, K.; Gas, S.; Barry, C.R.; et al. Deciphering the biology of Mycobacterium tuberculosis from the complete genome sequence. Nature 1998, 393, 537–544. [Google Scholar] [CrossRef]
- Sparks, I.L.; Derbyshire, K.M.; Jacobs, W.J.; Morita, Y.S. Mycobacterium smegmatis: The Vanguard of Mycobacterial Research. J. Bacteriol. 2023, 205, e33722. [Google Scholar] [CrossRef] [PubMed]
- Li, X.; Mei, H.; Chen, F.; Tang, Q.; Yu, Z.; Cao, X.; Andongma, B.T.; Chou, S.H.; He, J. Transcriptome Landscape of Mycobacterium smegmatis. Front. Microbiol. 2017, 8, 2505. [Google Scholar] [CrossRef] [PubMed]
- Jankute, M.; Cox, J.A.; Harrison, J.; Besra, G.S. Assembly of the Mycobacterial Cell Wall. Annu. Rev. Microbiol. 2015, 69, 405–423. [Google Scholar] [CrossRef] [PubMed]
- Rombouts, Y.; Brust, B.; Ojha, A.K.; Maes, E.; Coddeville, B.; Elass-Rochard, E.; Kremer, L.; Guerardel, Y. Exposure of mycobacteria to cell wall-inhibitory drugs decreases production of arabinoglycerolipid related to Mycolyl-arabinogalactan-peptidoglycan metabolism. J. Biol. Chem. 2012, 287, 11060–11069. [Google Scholar] [CrossRef]
- Hong, X.; Hopfinger, A.J. Construction, molecular modeling, and simulation of Mycobacterium tuberculosis cell walls. Biomacromolecules 2004, 5, 1052–1065. [Google Scholar] [CrossRef]
- Ojha, A.K.; Baughn, A.D.; Sambandan, D.; Hsu, T.; Trivelli, X.; Guerardel, Y.; Alahari, A.; Kremer, L.; Jacobs, W.J.; Hatfull, G.F. Growth of Mycobacterium tuberculosis biofilms containing free mycolic acids and harbouring drug-tolerant bacteria. Mol. Microbiol. 2008, 69, 164–174. [Google Scholar] [CrossRef]
- Ojha, A.; Anand, M.; Bhatt, A.; Kremer, L.; Jacobs, W.J.; Hatfull, G.F. GroEL1: A dedicated chaperone involved in mycolic acid biosynthesis during biofilm formation in mycobacteria. Cell 2005, 123, 861–873. [Google Scholar] [CrossRef]
- Chen, J.M.; German, G.J.; Alexander, D.C.; Ren, H.; Tan, T.; Liu, J. Roles of Lsr2 in colony morphology and biofilm formation of Mycobacterium smegmatis. J. Bacteriol. 2006, 188, 633–641. [Google Scholar] [CrossRef] [PubMed]
- Pacheco, S.A.; Hsu, F.F.; Powers, K.M.; Purdy, G.E. MmpL11 protein transports mycolic acid-containing lipids to the mycobacterial cell wall and contributes to biofilm formation in Mycobacterium smegmatis. J. Biol. Chem. 2013, 288, 24213–24222. [Google Scholar] [CrossRef]
- Li, W.; He, Z.G. LtmA, a novel cyclic di-GMP-responsive activator, broadly regulates the expression of lipid transport and metabolism genes in Mycobacterium smegmatis. Nucleic Acids Res. 2012, 40, 11292–11307. [Google Scholar] [CrossRef] [PubMed]
- Guo, M.; Feng, H.; Zhang, J.; Wang, W.; Wang, Y.; Li, Y.; Gao, C.; Chen, H.; Feng, Y.; He, Z.G. Dissecting transcription regulatory pathways through a new bacterial one-hybrid reporter system. Genome Res. 2009, 19, 1301–1308. [Google Scholar] [CrossRef] [PubMed]
- Holzheimer, M.; Buter, J.; Minnaard, A.J. Chemical Synthesis of Cell Wall Constituents of Mycobacterium tuberculosis. Chem. Rev. 2021, 121, 9554–9643. [Google Scholar] [CrossRef] [PubMed]
- Goude, R.; Parish, T. The genetics of cell wall biosynthesis in Mycobacterium tuberculosis. Future Microbiol. 2008, 3, 299–313. [Google Scholar] [CrossRef]
- Wang, Y.; Huang, Y.; Xue, C.; He, Y.; He, Z.G. ClpR protein-like regulator specifically recognizes RecA protein-independent promoter motif and broadly regulates expression of DNA damage-inducible genes in mycobacteria. J. Biol. Chem. 2011, 286, 31159–31167. [Google Scholar] [CrossRef]
- Yang, M.; Gao, C.; Cui, T.; An, J.; He, Z.G. A TetR-like regulator broadly affects the expressions of diverse genes in Mycobacterium smegmatis. Nucleic Acids Res. 2012, 40, 1009–1020. [Google Scholar] [CrossRef]
- Stover, C.K.; de la Cruz, V.F.; Fuerst, T.R.; Burlein, J.E.; Benson, L.A.; Bennett, L.T.; Bansal, G.P.; Young, J.F.; Lee, M.H.; Hatfull, G.F.; et al. New use of BCG for recombinant vaccines. Nature 1991, 351, 456–460. [Google Scholar] [CrossRef]
- Miller, J.H. Experiments in Molecular Genetics; Cold Spring Harbor Laboratory: Cold Spring Harbor, NY, USA, 1972. [Google Scholar]
- Li, W.; Cui, T.; Hu, L.; Wang, Z.; Li, Z.; He, Z.G. Cyclic diguanylate monophosphate directly binds to human siderocalin and inhibits its antibacterial activity. Nat. Commun. 2015, 6, 8330. [Google Scholar] [CrossRef]
- Li, W.; Li, M.; Hu, L.; Zhu, J.; Xie, Z.; Chen, J.; He, Z.G. HpoR, a novel c-di-GMP effective transcription factor, links the second messenger’s regulatory function to the mycobacterial antioxidant defense. Nucleic Acids Res. 2018, 46, 3595–3611. [Google Scholar] [CrossRef] [PubMed]
- O’Sullivan, D.M.; Nicoara, S.C.; Mutetwa, R.; Mungofa, S.; Lee, O.Y.; Minnikin, D.E.; Bardwell, M.W.; Corbett, E.L.; McNerney, R.; Morgan, G.H. Detection of Mycobacterium tuberculosis in sputum by gas chromatography-mass spectrometry of methyl mycocerosates released by thermochemolysis. PLoS ONE 2012, 7, e32836. [Google Scholar] [CrossRef] [PubMed]
- Cha, D.; Cheng, D.; Liu, M.; Zeng, Z.; Hu, X.; Guan, W. Analysis of fatty acids in sputum from patients with pulmonary tuberculosis using gas chromatography-mass spectrometry preceded by solid-phase microextraction and post-derivatization on the fiber. J. Chromatogr. A 2009, 1216, 1450–1457. [Google Scholar] [CrossRef] [PubMed]
- Wang, J.; Ge, P.; Qiang, L.; Tian, F.; Zhao, D.; Chai, Q.; Zhu, M.; Zhou, R.; Meng, G.; Iwakura, Y.; et al. The mycobacterial phosphatase PtpA regulates the expression of host genes and promotes cell proliferation. Nat. Commun. 2017, 8, 244. [Google Scholar] [CrossRef] [PubMed]
- Li, X.; Chen, L.; Liao, J.; Hui, J.; Li, W.; He, Z.G. A novel stress-inducible CmtR-ESX3-Zn(2+) regulatory pathway essential for survival of Mycobacterium bovis under oxidative stress. J. Biol. Chem. 2020, 295, 17083–17099. [Google Scholar] [CrossRef]
- Wang, J.; Li, B.X.; Ge, P.P.; Li, J.; Wang, Q.; Gao, G.F.; Qiu, X.B.; Liu, C.H. Mycobacterium tuberculosis suppresses innate immunity by coopting the host ubiquitin system. Nat. Immunol. 2015, 16, 237–245. [Google Scholar] [CrossRef]

Disclaimer/Publisher’s Note: The statements, opinions and data contained in all publications are solely those of the individual author(s) and contributor(s) and not of MDPI and/or the editor(s). MDPI and/or the editor(s) disclaim responsibility for any injury to people or property resulting from any ideas, methods, instructions or products referred to in the content. |
© 2023 by the authors. Licensee MDPI, Basel, Switzerland. This article is an open access article distributed under the terms and conditions of the Creative Commons Attribution (CC BY) license (https://creativecommons.org/licenses/by/4.0/).
Share and Cite
Wang, K.; Cui, X.; Ling, X.; Chen, J.; Zheng, J.; Xiang, Y.; Li, W. D-Xylose Blocks the Broad Negative Regulation of XylR on Lipid Metabolism and Affects Multiple Physiological Characteristics in Mycobacteria. Int. J. Mol. Sci. 2023, 24, 7086. https://doi.org/10.3390/ijms24087086
Wang K, Cui X, Ling X, Chen J, Zheng J, Xiang Y, Li W. D-Xylose Blocks the Broad Negative Regulation of XylR on Lipid Metabolism and Affects Multiple Physiological Characteristics in Mycobacteria. International Journal of Molecular Sciences. 2023; 24(8):7086. https://doi.org/10.3390/ijms24087086
Chicago/Turabian StyleWang, Kun, Xujie Cui, Xiaocui Ling, Jiarui Chen, Jiachen Zheng, Yuling Xiang, and Weihui Li. 2023. "D-Xylose Blocks the Broad Negative Regulation of XylR on Lipid Metabolism and Affects Multiple Physiological Characteristics in Mycobacteria" International Journal of Molecular Sciences 24, no. 8: 7086. https://doi.org/10.3390/ijms24087086
APA StyleWang, K., Cui, X., Ling, X., Chen, J., Zheng, J., Xiang, Y., & Li, W. (2023). D-Xylose Blocks the Broad Negative Regulation of XylR on Lipid Metabolism and Affects Multiple Physiological Characteristics in Mycobacteria. International Journal of Molecular Sciences, 24(8), 7086. https://doi.org/10.3390/ijms24087086
